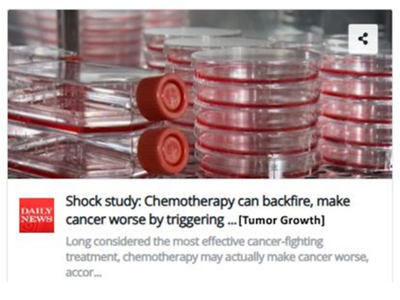
4

Atavistic oncology represents a novel scientific framework for understanding the retro-evolutionary origin and malignant traits of cancer cells. I question the validity of established cancer theories and treatments, offering a novel, non-toxic, curative approach known as “Atavistic Chemotherapy.” For the past 14 years, this novel approach has been evaluated in patients with a variety of cancer types.

Dr. Frank Arguello
Director, Atavistic Chemotherapy Clinical Trial.
Fmr. Assistant Professor of Oncology,
and of Pediatric Hematology and Oncology,
University of Rochester, Cancer Center. Rochester, New York.
Fmr. Senior Scientist, Drug Discovery, Division of Cancer Treatment
& Diagnosis, National Cancer Institute, NIH. Frederick, Maryland.
Dr. Frank Arguello
Director, Atavistic Chemotherapy Clinical Trial.
Fmr. Assistant Professor of Oncology,
and of Pediatric Hematology and Oncology,
University of Rochester, Cancer Center. Rochester, New York.
Fmr. Senior Scientist, Drug Discovery, Division of Cancer Treatment
& Diagnosis, National Cancer Institute, NIH. Frederick, Maryland.
Atavistic oncology represents a novel scientific framework for understanding the retro-evolutionary origin and malignant traits of cancer cells. I question the validity of established cancer theories and treatments, offering a novel, non-toxic, curative approach known as “Atavistic Chemotherapy.” For the past 14 years, this novel approach has been evaluated in patients with a variety of cancer types.

Dr. Frank Arguello
Director, Atavistic Chemotherapy Clinical Trial.
Fmr. Assistant Professor of Oncology,
and of Pediatric Hematology and Oncology,
University of Rochester, Cancer Center. Rochester, New York.
Fmr. Senior Scientist, Drug Discovery, Division of Cancer Treatment
& Diagnosis, National Cancer Institute, NIH. Frederick, Maryland.
Our Patients' Cancers Before and After Atavistic Chemotherapy
(Click Images to Enlarge)
Primary Diffuse B-Cell, EBV-Associated Lymphoma of the Brain.
Male (54 Y/O) had been under immunosuppression for the last 9 years following a lung transplant. In late November 2019, the patient experienced seizures and was rushed to the hospital. An MRI of head demonstrated a diffuse brain lesion (yellow arrows in images). Following a needle biopsy, the lesion was diagnosed as a primary B-Cell, EBV-Associated Lymphoma. The ‘before’ image is from an MRI of November 23, 2019, prior to initiation of atavistic chemotherapy. The ‘after’ image is an MRI twenty days of initiated atavistic chemotherapy.
Regression of Benign Lipoma During Atavistic Chemotherapy for a Malignant Brain Tumor:
Randy is a 45 Y/O patient who suffers from a Grade III Anaplastic Oligodendroglioma (a malignant brain tumor partially resected surgically in February 2020). Although the “Before and After” images related to the brain tumor results will be posted here soon, we wanted to show you an unexpected event. For years, the patient had had a slow growing mass below her left breast which was diagnosed clinically as a lipoma (a benign tumor formed by fat cells or adipocytes). During treatment with atavistic chemotherapy for his brain tumor, the patient noticed changes in his benign lipoma. He recorded these changes with photographs, starting after the first month of treatment. As you could see, the tumor underwent complete regression by the fifth month in atavistic chemotherapy. Atavistic chemotherapy may be helpful also in benign tumors. The reduction of body hair is due to the treatment.
Inflammatory Breast Cancer (part 1):
Angelina, a 58-year-old woman came to us with aggressive breast cancer. It had extensively invaded the skin and areola (the area around her nipple) of her right breast. The 'before' picture shows multiple raised lumps of cancerous tissue growing under the skin of her breast and areola. Most of her breast skin looks reddish because more blood is flowing to the area. The 'after' photo shows lots of necrotic (dead) cancerous tissue that had formed by four weeks after beginning atavistic chemotherapy.
Inflammatory Breast Cancer (part 2):
Angelina, the patient in the previous case study, continued her therapy with us. The 'before' picture shows a well-healing scab where the dead cancer tissue is beginning to separate from the healthy tissue. The ‘after’ photo shows the result: a healing wound in her right breast after the scab has come away. The picture was taken after completing atavistic chemotherapy.
Locally Advanced Breast Cancer:
Bertha, a 46-year-old woman, had decided against formal medical treatment for 4 years after her breast cancer was first diagnosed. She had pain and bleeding that forced her to accept conventional palliative chemotherapy during that time. Unfortunately, she stopped this treatment after 2 cycles as she was unable to tolerate the therapy. The 'before' photo shows that her entire left breast had been ‘digested’ by her cancer. A malignant ulcer had also developed in her affected breast, with bleeding and a putrid discharge. A large clot also caused the area to retract, resulting in an eye-like appearance. The 'after' photo shows her cancer’s complete clinical response within 6 months of beginning atavistic chemotherapy. This also led to noticeable fibrosis and scar retraction in the site.
Recurrent Stomach Cancer in the Abdominal Cavity:
This 54 Y/O patient underwent an extensive surgery for a primary cancer of the stomach. Approximately 90% of his stomach was removed, together with a segment of the liver, the entire spleen, gallbladder, and a portion of the colon. However, cancer cells were found by pathology in the margins of the resected stomach. The before photo shows a PET-CT scan image two month after surgery. The image depicts the presence of tumor metabolic activity in the left upper quadrant of the abdomen suggestive of recurrent metastatic deposits. The after photograph represents a PET-CT scan image three months after the initiation of atavistic chemotherapy demonstrating that the increased metabolic activity in the upper left quadrant has disappeared.
Recurrent Breast Cancer Invading Throughout the Skin of the Patient (part 2):
Gloria, a 43-year-old woman, developed recurrent breast cancer around a surgical scar. For two years, and despite several cycles of traditional chemotherapy, the cancer continued invading and migrating throughout the skin of her chest and abdomen (front and back), causing a constant burning sensation and itching. The ‘before’ photos depict the changes to her abdominal and chest skin. Multiple skin biopsies revealed that the entire area was affected by cancerous cells. The 'after' photo shows Gloria’s amazing progress two months after beginning atavistic chemotherapy.
Recurrent Breast Cancer Invading Throughout the Skin of the Patient: part 1:
Gloria, a 43-year-old woman, developed recurrent breast cancer around a surgical scar. For two years, and despite several cycles of traditional chemotherapy, the cancer continued invading and migrating throughout the skin of her chest and abdomen (front and back), causing a constant burning sensation and itching. The ‘before’ photos depict the changes to her abdominal and chest skin. Multiple skin biopsies revealed that the entire area was affected by cancerous cells. The 'after' photo shows Gloria’s amazing progress two months after beginning atavistic chemotherapy.
Lymph Node Metastases in the Mediastinum from a Malignant Melanoma.
Alice, a 55-year-old woman, came to us with multiple metastatic tumors in the lymph nodes of the center of her chest (mediastinum). The yellow arrows indicate her melanoma-enlarged lymph nodes. The 'after' photo is one year after she began atavistic chemotherapy, and when the treatment was discontinued. As you can see, lymph nodes are now calcified (hardened) where the melanoma cancer cells have died.
Glioblastoma Multiforme Partially Removed Surgically
Judith is a 32-year-old woman who was diagnosed with an aggressive brain tumor (glioblastoma). The 'before' MRI image was taken around 20 days after an operation to remove approximately 60% of the tumor. The 'after' MRI image follows six months of atavistic chemotherapy. Her treatment was complete in just eight months.
Stage IV, Breast Cancer:
Alejandra is a 45-year-old woman who had been diagnosed with invasive triple-positive breast cancer. She wasn’t able to tolerate any traditional chemotherapy in preparation for a radical mastectomy. As a result, the mastectomy never took place. The 'before' image is 1.5 years after her first diagnosis, and almost a year after abandoning traditional chemotherapy. The 'after' image shows her progress four months after choosing atavistic chemotherapy.
Locally Advanced Breast Cancer:
These pictures show Alice, who is a 75-year-old woman diagnosed with invasive triple-positive breast cancer. The patient did not want to have a radical mastectomy. The 'before' image shows her cancer four years after being diagnosed. The 'after' image was taken eight months after beginning atavistic chemotherapy.
Recurrent Triple-Negative Breast Cancer:
Linda is a 59-year-old woman who had a second recurrence of cancer in the same place. The first recurrence happened 6 months after her original lump was removed. The second recurrence occurred 6 months after she had had a radical mastectomy, traditional chemotherapy and radiation. The 'before' picture shows many raised and hyperemic (red) areas of cancerous tissue growing around her surgical scar. The 'after' image illustrates a dramatic change following four months of atavistic chemotherapy.
Recurrent Breast Cancer at Site of Mastectomy and Distant Metastases:
Susan is a 40-year-old woman whose cancer returned in the same area two years after she had a radical mastectomy, traditional chemotherapy and radiation. The 'before' image shows the extensive ulceration of her skin about six months she was diagnosed. The 'after' image was taken six months after beginning atavistic chemotherapy.
Multiple Lung Metastases from a Colon Cancer:
Terry is a 50-year-old man who came to us with multiple lung metastases (secondary growths) from a colon cancer that had been surgically removed two years earlier. The 'before' image is of a chest CT scan showing large metastatic (secondary) tumors in his lungs (yellow arrows). The 'after' image is a chest CT scan four months after initiating atavistic chemotherapy.
Extramammary Perianal Paget's Disease (rare skin cancer).
This anonymous female patient of 74 years of age, was diagnosed with this rare skin cancer of the perianal and perineal region in June 2020. Different to other skin cancers, this is an adenocarcinoma. The origin of the neoplastic cells could be apocrine glands or epithelial stem cells. Skin areas rich in apocrine glands such as the genital region are typical sites of extramammary Paget’s disease. Surgery was not an option, and the patient rejected radiation and/or traditional chemotherapy. The ‘before’ picture was taken on June 13, 2020. Atavistic chemotherapy was initiated on June 16, 2020. The ‘after’ photo was taken on July 13, 2020 (27 days in atavistic chemotherapy).
Terminal and Heavily Treated Metastatic Ocular Melanoma with Massive Liver and Bone Metastases
A 34-year-old female patient from Georgia was diagnosed with ocular (uveal/choroidal) melanoma of the left eye at the age of 31. The affected eye underwent enucleation and was subsequently replaced with a prosthesis. Metastases to the liver and bones were identified two years later. The patient received treatment at the Acibadem Clinic in Istanbul, Turkey, initially with KEYTRUDA and later with GLEEVEC. Following a year of persistent tumor progression and declining health, the patient received treatment at Heidelberg University Hospital in Germany through intrahepatic arterial infusion of melphalan. In July 2017, the patient reached out to me. Typically, I do not enroll patients with a history of extensive use of traditional chemotherapy due to the development of resistance mechanisms and increased cancer aggression. However, as a young mother, I chose to make an exemption. Doctors in Georgia discouraged the patient to continue with my treatment. She died in Georgia; however, I present these images to demonstrate the efficacy of atavistic chemotherapy despite the extensive cancer burden.
Recurrent Vulval Cancer in a Patient with a History of Vulvar Lichen Sclerosus et Atrophicus
The patient, a 57-year-old female, has been suffering from vulvar lichen sclerosus et atrophicus for seven years. A lump appeared in the labia majora of her vulva in early 2019. It was biopsied and diagnosed as a well-differentiated squamous cell carcinoma. The patient underwent a partial radical vulvectomy with bilateral sentinel inguinal femoral lymph node dissection. Ultrasound vulvar and perianal ablation were also carried out. Cancer cells were found invading the surgical margins during a microscopic analysis of the surgical specimen. Three months later a new lesion appeared in the surgical bed and was confirmed by biopsy to be a recurrence. The patient was offered more surgery, chemotherapy, and radiation, but she declined. In August of 2019, she enrolled in our clinical trial. After three months of atavistic chemotherapy, the vulvar area appears healthier than it did before treatment, and the patient remains cancer-free as of 2025. The lichen sclerosus is still affecting the patient.
Localized Primary Breast Cancer
Female patient (52 years old) with a mammography and ultrasound describing a worrisome irregular solid region of approximately 15.5 x 7.4 x 10.3 mm and located in the left breast at 3 o'clock, BIRADS 4 (see below). Core Needle Biopsy reveals an invasive ductal carcinoma . Cancer cells are E&P positive and Her-2 negative in immunohistochemistry. The patient desires to avoid a mastectomy and traditional chemotherapy/radiation. The patient is invited to participate in the atavistic chemotherapy trial. After one month of atavistic chemotherapy, a radiologist is unable to suspect malignancy following a new ultrasound obtained from a different radiological facility. The patient was treated for three months, and a mammogram is performed at the fourth month.
Don't Waste Your Life!
The Truth About Conventional Cancer Treatments
(Click Images for Full Report)
Don't Waste Your Life!
The Truth About Conventional Cancer Treatments
Voices of Survivors
Can Atavistic Chemotherapy Save Patients with Advanced or Terminal Cancer?
These Patients Beat the Odds
and Would Like to Share Their Stories with You!!

ALICE
Stage IV Malignant Melanoma
(metastases to lymph nodes and lungs)
Alice, was unsuccessfully treated with surgeries, radiation, chemotherapy, and immunotherapy for two years. Discharged as a hopeless case from Princess Margaret Hospital, University of Toronto. Toronto, Ontario, Canada, in 2013.
Alice was treated with Atavistic Chemotherapy in 2013. Contact Information available upon request. Complete clinical history and radiological images available upon request by an oncologist.

BARBARA
Stage IV Malignant Melanoma
(Five large metastases in the brain, four years after removal of the primary tumor)
Four Years after the removal of a cutaneous melanoma, in 2014, Barbara experienced seizures and was transported to the hospital. Multiple large metastases were found in her brain, one of which was bleeding. She underwent neurosurgery to excise the hemorrhaging metastasis at Vancouver General Hospital. Vancouver, British Columbia. Canada. Barbara was deemed terminal, and no additional therapy was offered.
Barbara was treated with Atavistic Chemotherapy in 2014. Contact Information available upon request. Complete clinical history and radiological images available upon request by an oncologist.

LOURDES
Stage IV Carcinoma of the Adrenal Glands
(Multiple metastases in the peritoneal cavity)
In 2017, Lourdes underwent total left nephrectomy and removal of the left adrenal gland due to the presence of an 11-cm tumor mass. The pathology report was obtained from the Department of Pathology at the University of Michigan. Ann Arbor, Michigan, described the lesion as an adrenal cortical carcinoma, oncocytic type. A PET-CT scan at the National Cancer Institute, Bethesda, MD, reported multiple metastatic lesions in the peritoneal cavity. To our knowledge, this is the only surviving patient to an adrenocortical carcinoma in medical history.
Lourdes was treated with Atavistic Chemotherapy in 2018. Contact Information available upon request. Complete clinical history and radiological images available upon request by an oncologist.

ANA VICTORIA
High-Grade Mucinous Adenocarcinoma
of the Ovary
Ana Victoria, 21, had surgery in May 2023 to remove a large cystic tumor mass that was later diagnosed as High-Grade Mucinous Adenocarcinoma (G3). At only 21 years of age and unmarried, she wanted to avoid a total abdominal hysterectomy and bilateral salpingo-oophorectomy, a standard procedure after an ovarian cancer diagnosis (she wanted to have children and avoid becoming a menopausal woman at 21). Thus, she enrolled in the Atavistic Chemotherapy Clinical Trial.
Ana Victoria was treated with Atavistic Chemotherapy in 2023. Contact Information available upon request. Complete clinical history and radiological images available upon request by an oncologist.

MARISOL
Endometroid Carcinoma of the Ovary
(Stage II, Spread into the peritoneal cavity)
Marisol underwent resection surgery at a private hospital for a potentially benign ovarian tumor. However, it turned out to be a malignant tumor that had already ruptured its capsule, and cancer cells were growing on the peritoneal cavity.
Marisol was treated with Atavistic Chemotherapy in 2017. Contact Information available upon request. Complete clinical history and radiological images available upon request by an oncologist.

B.H.
Recurrent Squamous Cell Carcinoma
of the Vulva
B.H. underwent two separate surgeries in 2019 at the Billings Clinic, Billings, Montana, USA, to remove the primary and later a recurrent vulvar carcinoma. After a second recurrence, she contacted Dr. Arguello to avoid more extensive surgery, traditional chemotherapy, and radiation, which would likely fail, as occurs with recurrent malignant lesions in this area.
B.H., was treated with Atavistic Chemotherapy in 2019. Contact Information available upon request. Complete clinical history and radiological images available upon request by an oncologist.

SALOMON
Diffuse B-Cell, EBV-Associated Lymphoma
of the Brain
In 2019, Salomon unexpectedly suffered seizures and was found to have a Diffuse B-Cell, EBV-Associated Lymphoma of the Brain following a needle biopsy at the Saskatoon Cancer Center. Saskatoon, Saskatchewan, Canada.
Salomon was treated with Atavistic Chemotherapy in 2019. Contact Information available upon request. Complete clinical history and radiological images available upon request by an oncologist.

ISAURA
Breast Cancer Stage IIIc
Isaura was diagnosed with breast cancer in 2020. However, she decided not to seek medical care for four years. It was not until 2024 when she became interested in our atavistic chemotherapy clinical trial. The patient underwent a mastectomy and removal of the axillary lymph nodes to reduce the burden of cancer that had accumulated in her breast over four years. The cancer was classified as Stage IIIc, with 18 out of 22 lymph nodes colonized by metastatic cancer cells.
Isaura was treated with Atavistic Chemotherapy in 2019. Contact Information available upon request. Complete clinical history and radiological images available upon request by an oncologist.


This Work is Dedicated to the Loving Memory of My Mother, Who Died of Gallbladder Cancer at the Age of 50, When I Was a 21-Year-Old Medical Student

If only the love of your young children could have saved you, you certainly would not have died. But our love and tears were not enough. I never understood why God took you so early from our lives, until now. This book would have never been written. Let’s hope this book and the subsequent work derived from these concepts prevent other families from experiencing the pain and sorrows that we went through with your premature death.
Address
U.S Administrative and Enrolment Office:
The Atavistic Chemotherapy Trial
Bethesda Metro Center
Bethesda, Maryland 20814
Call us:
Tel: 301 – 760 – 7777 (Maryland)
Fax: (301) 690 – 9000 (Maryland)
Clinical Trial Sites:
Dr. Frank Arguello (Medical Atavistic Oncology)
Dr. Salvador Belmont (Surgical Atavistic Oncology)
HOSPITAL LOS ANGELES
Av. Campos Eliseos 9371
Cd Juárez, Chih., 32472
Mexico